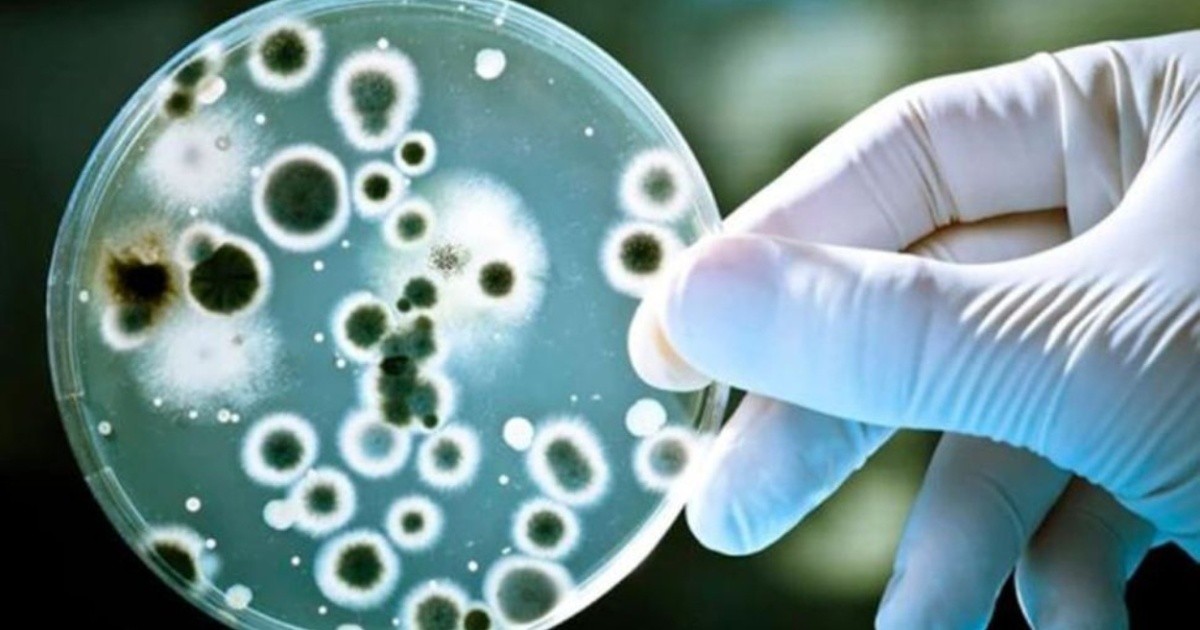

he Ministry of Health I mentioned this Saturday that they have been notified 118 cases sure who Invasive infection with Streptococcus pyogenes In Argentina, a gram-positive bacterium is the most common bacterial cause of acute pharyngitis and skin infections such as impetigo, cellulitis, and scarlet fever, of which 16 of them died.
Regarding confirmed cases of invasive infection with Streptococcus pyogenes in previous years (2019-2022), the highest number of cases was recorded in 2022 (the closed year) with 75 cases reported; So the number 2023 is an increase of 281% compared to the same period in 2019, according to Tellam.
This is happening in the international context as the World Health Organization (WHO) reported on 8 December 2022 that at least five Member States from the European Region (France, Ireland, Netherlands, Sweden and United Kingdom of Great Britain and Northern Ireland) have reported an increase in the number of cases of invasive disease caused by Streptococcus of group A (Streptococcus pyogenes) and on December 19, 2022 the Pan American Health Organization (PAHO) also issued a statement due to the increase in cases registered in Uruguay.
Streptococcus pyogenes, an invasive infection
Streptococcus pyogenes, also known as group A Streptococcus, generally causes mild illnesses such as tonsillitis, pharyngitis, impetigo, cellulitis, and scarlet fever. However, in rare cases, the infection can lead to an invasive disease that can lead to life-threatening conditions, being responsible for more than 500,000 deaths annually worldwide.
Transmission occurs through close contact with an infected person It can be transmitted by coughing, sneezing, or skin contact. The incubation period for the disease varies, depending on the clinical presentation, between one and three days. Treating infected people with antibiotics for at least 24 hours usually eliminates their ability to spread.
Pharyngitis is diagnosed by bacterial cultures and treated with antibiotics. Hand hygiene and personal hygiene can help control transmission.
the symptoms from pharyngitis throat pain; Fever; headache; Stomach ache; Vomiting and nausea; Redness of the pharynx and tonsils. Bad breath Swelling nodes in the neck.
With regard to scarlet fever, the most common symptoms are redness and sore throat. fever (38.3°C or more); A red rash with the texture of sandpaper. Deep red skin in the armpit, elbow and groin folds. a white coating on the tongue or back of the throat; Raspberry tongue. headache; nausea or vomiting; swollen glands; Body aches
In the presence of some of these symptoms, it is important to avoid self-medication with antibiotics and consult a doctor to get a timely diagnosis. If a medical indication for antibiotic treatment is received, it is essential to complete the scheme (do not shorten or abandon treatment prematurely), because inappropriate use of antibiotics promotes bacterial resistance, a fact that threatens their effectiveness in the future.
Patients should avoid going to public places (work, school) and limit home contacts. It is also important to wash your hands often; Do not share items for personal use (cutlery, glasses, towels, etc.) and ventilate the environments appropriately and regularly. Finally, the National Health Portfolio also states that all people should be up to date on their influenza and coronavirus vaccine, especially those with risk factors.

:quality(85)/cloudfront-us-east-1.images.arcpublishing.com/infobae/53RFOA42FX7KAGGMIMASNRUUCM.jpg)
